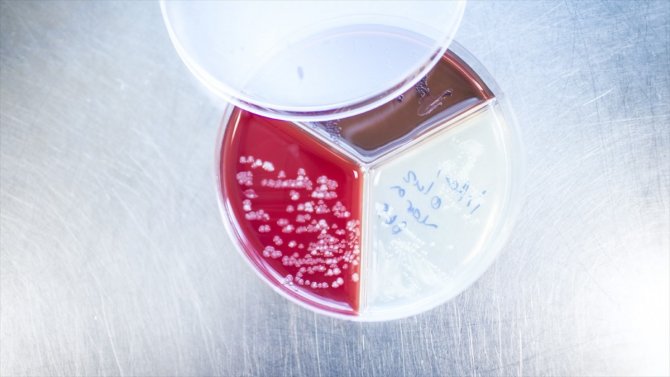
Türk bilim insanlarından Kovid-19 araştırmalarına katkı verecek yeni keşif

Türk bilim insanlarından Kovid-19 araştırmalarına katkı verecek yeni keşif
ANKARA (AA) - Bilkent Üniversitesi Ulusal Nanoteknoloji Araştırma Merkezi (UNAM) araştırmacıları, daha önce bilim dünyası için bir sır olan atomlardan insan hücrelerine kadar uzanan bir dizi malzemenin fizik ve matematik kanunları çerçevesinde nasıl bir araya geldiğini ortaya çıkararak bilimsel keşfe imza attı.
Dünyanın her köşesinden bilim insanları, disiplinlerarası bir eforla Kovid-19 salgınının nasıl ortaya çıktığı, büyüdüğü ve ne zaman biteceği konusunda araştırmalar yaparken Türk bilim insanları bu bilimsel yürüyüşe önemli katkı sağlayacak bir keşif yaptı.
Bilkent Üniversitesi UNAM araştırmacıları, dünyanın en prestijli bilim dergilerinden Nature Physics'te yayımladıkları makaleyle yeni keşiflerini bilim dünyasına duyurdu.
Makalede, Bilkent Üniversitesi-UNAM, Fizik ve Elektrik-Elektronik Mühendisliği'nden Doç. Dr. Ömer İlday, Bilkent Üniversitesi-UNAM, Fizik, Elektrik ve Elektronik Mühendisliği Bölümleri ve NTU Singapore'dan Prof. Dr. Hilmi Volkan Demir, Bilkent Üniversitesi Moleküler Biyoloji ve Genetik Bölümü ve Güney Karolina Üniversitesinden Doç. Dr. Özgür Şahin, Ankara Üniversitesi Biyoteknoloji Enstitüsü'nden Doktor Öğretim Üyesi Doruk Engin ve Bilkent Üniversitesi UNAM Doktor Öğretim Üyesi Serim İlday'ın imzası bulunuyor.
Makalede birkaç atom büyüklüğündeki kuantum noktalarından yaklaşık 100 trilyon atom büyüklüğündeki insan hücrelerine kadar uzanan bir dizi malzemenin fizik ve matematik kanunları çerçevesinde nasıl bir araya geldikleri ilk kez gösterildi.
Türk bilim insanları, sadece bu keşifle kalmayıp bu kanunların ekonomi, ekoloji, sosyoloji gibi birbirinden tamamen bağımsız sistemlerde de geçerli olduğunu gösterdi.
"Biyoteknolojiden nanoteknolojiye devrimsel ilerlemenin önü açılabilir"
Serim İlday, keşiflerine ilişkin AA muhabirine yaptığı açıklamada, geliştirdikleri metodun biyoteknolojiden nanoteknolojiye birçok alanda devrimsel ilerlemelerin önünü açabileceğini ifade etti.
İlday, geliştirdikleri sistemle canlı insan hücresi ve mikroorganizmayı saniyeler içinde bir yerden bir yere taşıyabildiklerini, karışık halde bulunan bakteri topluluklarını birbirlerinden ayırabildiklerini belirtti.
Geliştirdikleri algoritmanın Kovid-19'la ilgili laboratuvar çalışmalarından yayılım haritalarına kadar pek çok alanda kullanılabileceğini belirten İlday, şöyle konuştu:
"Bu metot ile hızlı enfeksiyon tanısı yapılabileceğini öngörüyoruz. Ekip olarak, metodun pratik uygulamaları yanında geliştirdiğimiz matematik modelin de epidemik hastalıkların ortaya çıkışı ve seyri konusunda ilginç bağlantıları olduğunu gördük. Çalışma yapıldığı zaman ortada Kovid-19 pandemisi yoktu. Ancak sonradan yaptığımız ön çalışmalarda bulgularımızın, pandeminin yayılması ile ilişkili olduğunu gördük. Kovid-19 günlük hasta sayısı verileri S-eğrisi adı verilen bir dağılım oluştururken bu dağılımdan sapmalar da Tracy-Widom istatistikleri gösteriyordu, tıpkı makalemizde gösterdiğimiz gibi. Eğer Kovid-19'un S-eğrisi ve Tracy-Widom istatistikleri ile bağlantısı anlaşılabilirse pandeminin seyri öngörülebilir ve önlemlenmesi konularında bilinçli adımlar atılabilir."
Kaynak:Anadolu Ajansı

Türkçe karakter kullanılmayan ve büyük harflerle yazılmış yorumlar onaylanmamaktadır.